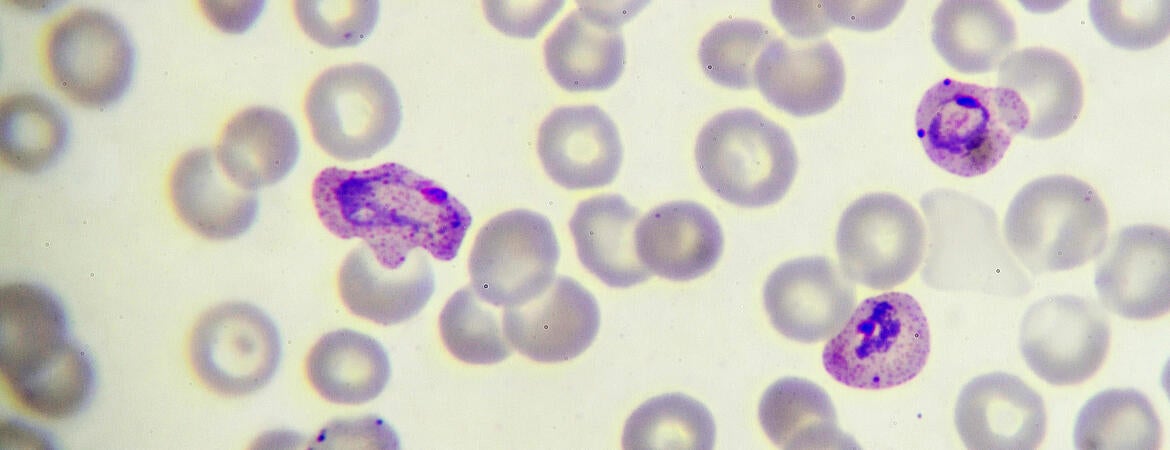
Malaria parasite in blood film

New work by a team led by scientists at the University of California, Riverside, has taken research one step closer to designing new therapies to fight and eradicate malaria thanks to a lab technique called R-DeeP.
The team is studying RNA-dependent proteins — assemblies of RNA molecules and proteins that are critical for cell survival. These RNA-protein complexes play fundamental roles in many cellular processes.
In Plasmodium falciparum, the deadliest human malaria parasite, however, scientists have been able to identify and characterize only a limited number of RNA-dependent proteins due to the complexity of the parasite life cycle progression and limited tools available to efficiently edit the parasite genome.
Now, using a comprehensive “molecular search tool” called R-DeeP, Karine Le Roch, and her colleagues have identified and characterized 898 RNA-dependent proteins in P. falciparum, including uncharacterized and parasite-specific proteins, which could lead to novel therapeutic targets against malaria. Study results appear today in Nature Communications.
“We also validated that one novel parasite-specific RNA-binding protein, PF3D7_0823200, interacts with various Plasmodium transcripts involved in controlling virulence,” said Le Roch, a professor of molecular, cell and systems biology and director of the UCR Center for Infectious Disease and Vector Research. “This RNA-binding protein could be targeted by new drugs and is, therefore, of interest in the fight against malaria.”
During transcription, a gene’s DNA sequence is copied by enzymes to make an RNA molecule. Of the 898 RNA-dependent proteins the researchers identified, only 39% of them had already been identified as associated with RNA.
“Our study provides the first snapshot of the Plasmodium protein-protein and protein-RNA interaction network in the parasite,” Le Roch said. “These generated R-DeeP results highlight the importance of RNA in many biological pathways in the parasite and identify new targets for combating malaria.”
Le Roch was joined in the study by Thomas Hollin, Steven Abel, and Jacques Prudhomme of UCR; Charles Banks and Laurence Florens of the Stowers Institute for Medical Research in Missouri; and Borislav Hristov, Kianna Hales, and William Stafford Noble of the University of Washington in Seattle.
The research was funded by the National Institutes of Allergy and Infectious Diseases of the National Institutes of Health and UCR.
The title of the research paper is “Proteome-Wide Identification of RNA-Dependent Proteins and An Emerging Role for RNAs in Plasmodium falciparum Protein Complexes.”
Header image credit: jarun011/iStock/Getty Images Plus.




